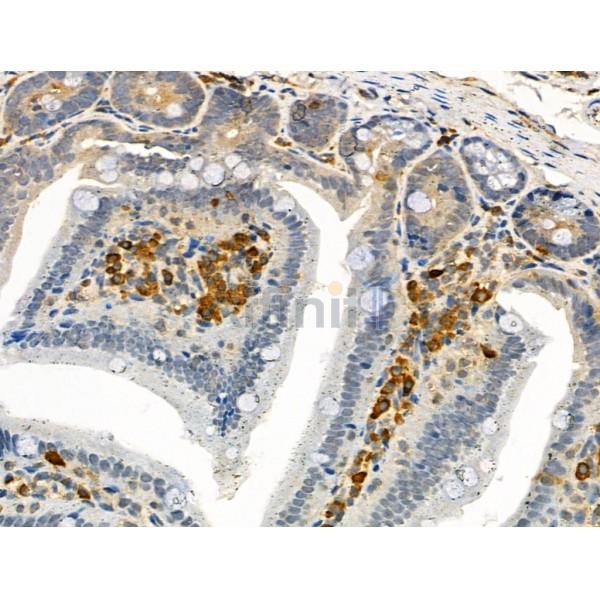
Phospho-TPOR (Tyr626) Antibody - AF4429 at 1/100 staining Mouse colorectal tissue by IHC-P.

Phospho-TPOR (Tyr626) Antibody - #AF4429
| Product: | Phospho-TPOR (Tyr626) Antibody |
| Catalog: | AF4429 |
| Description: | Rabbit polyclonal antibody to Phospho-TPOR (Tyr626) |
| Application: | WB IHC |
| Reactivity: | Human, Mouse, Rat |
| Prediction: | Bovine, Sheep |
| Mol.Wt.: | 85-90kDa; 71kD(Calculated). |
| Uniprot: | P40238 |
| RRID: | AB_2844493 |
Related Downloads
Protocols
Product Info
*The optimal dilutions should be determined by the end user. For optimal experimental results, antibody reuse is not recommended.
*Tips:
WB: For western blot detection of denatured protein samples. IHC: For immunohistochemical detection of paraffin sections (IHC-p) or frozen sections (IHC-f) of tissue samples. IF/ICC: For immunofluorescence detection of cell samples. ELISA(peptide): For ELISA detection of antigenic peptide.
Cite Format: Affinity Biosciences Cat# AF4429, RRID:AB_2844493.
Fold/Unfold
C MPL; CD110; mpl; MPLV; Myeloproliferative leukemia protein; Myeloproliferative leukemia virus oncogene; Proto-oncogene c-Mpl; THCYT2; Thrombopoietin receptor; TPO R; TPO-R; TPOR; TPOR_HUMAN;
Immunogens
A synthesized peptide derived from human TPOR around the phosphorylation site of Tyr626.
Expressed at a low level in a large number of cells of hematopoietic origin. Isoform 1 and isoform 2 are always found to be coexpressed.
- P40238 TPOR_HUMAN:
- Protein BLAST With
- NCBI/
- ExPASy/
- Uniprot
MPSWALFMVTSCLLLAPQNLAQVSSQDVSLLASDSEPLKCFSRTFEDLTCFWDEEEAAPSGTYQLLYAYPREKPRACPLSSQSMPHFGTRYVCQFPDQEEVRLFFPLHLWVKNVFLNQTRTQRVLFVDSVGLPAPPSIIKAMGGSQPGELQISWEEPAPEISDFLRYELRYGPRDPKNSTGPTVIQLIATETCCPALQRPHSASALDQSPCAQPTMPWQDGPKQTSPSREASALTAEGGSCLISGLQPGNSYWLQLRSEPDGISLGGSWGSWSLPVTVDLPGDAVALGLQCFTLDLKNVTCQWQQQDHASSQGFFYHSRARCCPRDRYPIWENCEEEEKTNPGLQTPQFSRCHFKSRNDSIIHILVEVTTAPGTVHSYLGSPFWIHQAVRLPTPNLHWREISSGHLELEWQHPSSWAAQETCYQLRYTGEGHQDWKVLEPPLGARGGTLELRPRSRYRLQLRARLNGPTYQGPWSSWSDPTRVETATETAWISLVTALHLVLGLSAVLGLLLLRWQFPAHYRRLRHALWPSLPDLHRVLGQYLRDTAALSPPKATVSDTCEEVEPSLLEILPKSSERTPLPLCSSQAQMDYRRLQPSCLGTMPLSVCPPMAESGSCCTTHIANHSYLPLSYWQQP
Predictions
Score>80(red) has high confidence and is suggested to be used for WB detection. *The prediction model is mainly based on the alignment of immunogen sequences, the results are for reference only, not as the basis of quality assurance.
High(score>80) Medium(80>score>50) Low(score<50) No confidence
Research Backgrounds
Receptor for thrombopoietin that acts as a primary regulator of megakaryopoiesis and platelet production. May represent a regulatory molecule specific for TPO-R-dependent immune responses.
Ubiquitination at Lys-553 and Lys-573 targets MPL for degradation by both the lysosomal and proteasomal pathways. The E3 ubiquitin-protein ligase CBL significantly contributes to this ubiquitination.
Cell membrane>Single-pass type I membrane protein. Golgi apparatus. Cell surface.
Expressed at a low level in a large number of cells of hematopoietic origin. Isoform 1 and isoform 2 are always found to be coexpressed.
The WSXWS motif appears to be necessary for proper protein folding and thereby efficient intracellular transport and cell-surface receptor binding.
The box 1 motif is required for JAK interaction and/or activation.
Belongs to the type I cytokine receptor family. Type 1 subfamily.
Research Fields
· Environmental Information Processing > Signaling molecules and interaction > Cytokine-cytokine receptor interaction. (View pathway)
· Environmental Information Processing > Signal transduction > Jak-STAT signaling pathway. (View pathway)
Restrictive clause
Affinity Biosciences tests all products strictly. Citations are provided as a resource for additional applications that have not been validated by Affinity Biosciences. Please choose the appropriate format for each application and consult Materials and Methods sections for additional details about the use of any product in these publications.
For Research Use Only.
Not for use in diagnostic or therapeutic procedures. Not for resale. Not for distribution without written consent. Affinity Biosciences will not be held responsible for patent infringement or other violations that may occur with the use of our products. Affinity Biosciences, Affinity Biosciences Logo and all other trademarks are the property of Affinity Biosciences LTD.